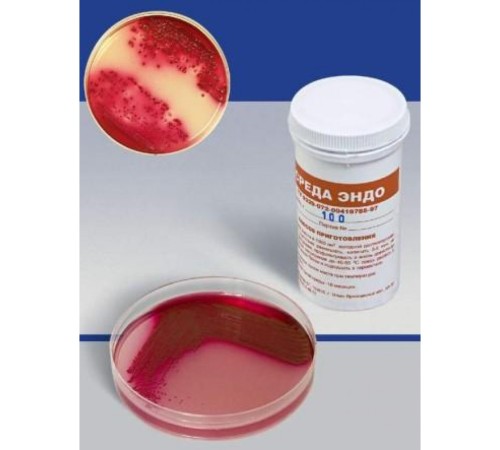

Не является лекарственным (фармацевтическим) препаратом. Не является БАД.
Не предназначен для проведения любых медицинских исследований или процедур.
Продажу химических реактивов осуществляем только юридическим лицам.
Состав:
• Пептон сухой ферментативный
• Натрий хлористый
• Экстракт кормовых дрожжей
• Фуксин основной
• Сахар молочный (лактоза)
• Натрий фосфорнокислый двузамещенный
• Натрий сернистокислый безводный
• Агар микробиологический
Питательная среда для выделения и дифференциации энтеробактерий, сухая (среда Эндо) - мелкодисперсный порошок светло-сиреневого цвета, гигроскопичен, чувствителен к свету.
Способ применения: Препарат в количестве 33 г размешивают в 1 дм3 воды очищенной, кипятят до полного расплавления агара в течение 2 - 3 минут, фильтруют и снова доводят до кипения. Среду охлаждают до температуры (47,5±2,5) °С, разливают в стерильные чашки Петри (ГОСТ 25336-82). После застывания среду, соблюдая правила асептики, подсушивают при температуре (37+1) °С в течение (50±10) минут. Готовая среда должна быть прозрачной и иметь бледно-розовый цвет.
Расход среды 40 г/дм3.Хранить в герметично закрытой упаковке в помещении с относительной влажностью воздуха не более 60 % и температурой от 5 до 25 °С.
Срок годности – 2 года..Фасовка в пластиковые банки по 500 г.
Цена дана за 1 упаковку с учетом НДС 20 %.
Нет отзывов об этом товаре.
Нет вопросов об этом товаре.
Доставка заказов осуществляется в любые регионы Российской Федерации и страны СНГ.
Цены на нашем сайте указаны с учетом НДС (20% либо 10%).
Оплата заказов производится только в безналичной форме на расчетный счет в рублях Российской Федерации на основании выставленного Счета.
Для бюджетных организаций и государственных структур предусмотрены особые условия оплаты.
Постоянным клиентам предоставляются скидки и индивидуальный порядок расчетов.
Внимание! В связи с нестабильным курсом валют и изменением цен у производителей, просим окончательную стоимость продукции уточнять у наших менеджеров.
Варианты доставки:
Самовывоз со склада в городе Клин
Адрес выдачи: Московская область, г. Клин, ул. Захватаева, д. 4, офис 101
Контактный телефон: +7 (977) 407-05-96
Доставка по Клину и Клинскому району – бесплатно
Доставка по Москве – 1 500 рублей
Доставка любыми транспортными компаниями, службами экспресс-доставки. Стоимость рассчитывается индивидуально для каждого заказа в соответствии с установленными тарифами транспортной компании. Все грузы застрахованы.
Компания "КомплектСнаб является официальным поставщиком от производителя НПЦ «Биокомпас-С». Вы всегда можете получить бесплатную консультацию по продукции, получить КП и задать вопросы по подбору аналогов продукции.